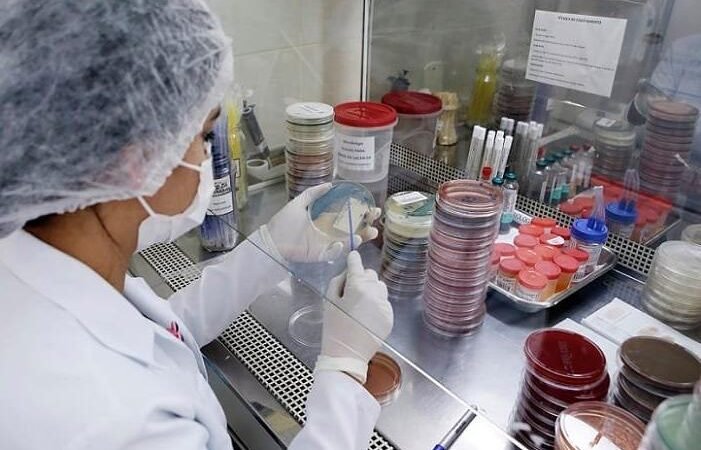
Oportunidades de Carreira para Técnicos no Instituto de Saúde Oportunidades de Carreira para Técnicos no Instituto de Saúde

Por Bruno de Freitas Moura – RJ Por Bruno de Freitas Moura – RJ Nos
Autor: Misto Brasil
Concurso Público da Companhia Docas do Ceará: Inscrições Abertas para 45 Vagas de Nível Superior
Impulsionado pelo comércio varejista, setor de serviços e baixas taxas de desemprego, o Nordeste lidera
Competição de Habilidades Técnicas: Jovens Talentos Brasileiros Disputam Vaga para a Etapa Mundial em Xangai
Do Sonho à Tela: Criando Cinema de Alta Qualidade com Orçamento Reduzido O workshop “Do
A Neoenergia Pernambuco estabelece um marco histórico como a primeira distribuidora de energia elétrica do
O mercado de imóveis comerciais no Brasil, que inclui salas e conjuntos de até 200
Aumento nos Preços das Passagens de Ônibus: Um Desafio para os Passageiros do Entorno do
Os usuários do transporte público que se deslocam entre as cidades do Entorno e o
Inscrições Abertas: Oportunidades no IgesDF para Profissionais da Saúde O Instituto de Gestão Estratégica de